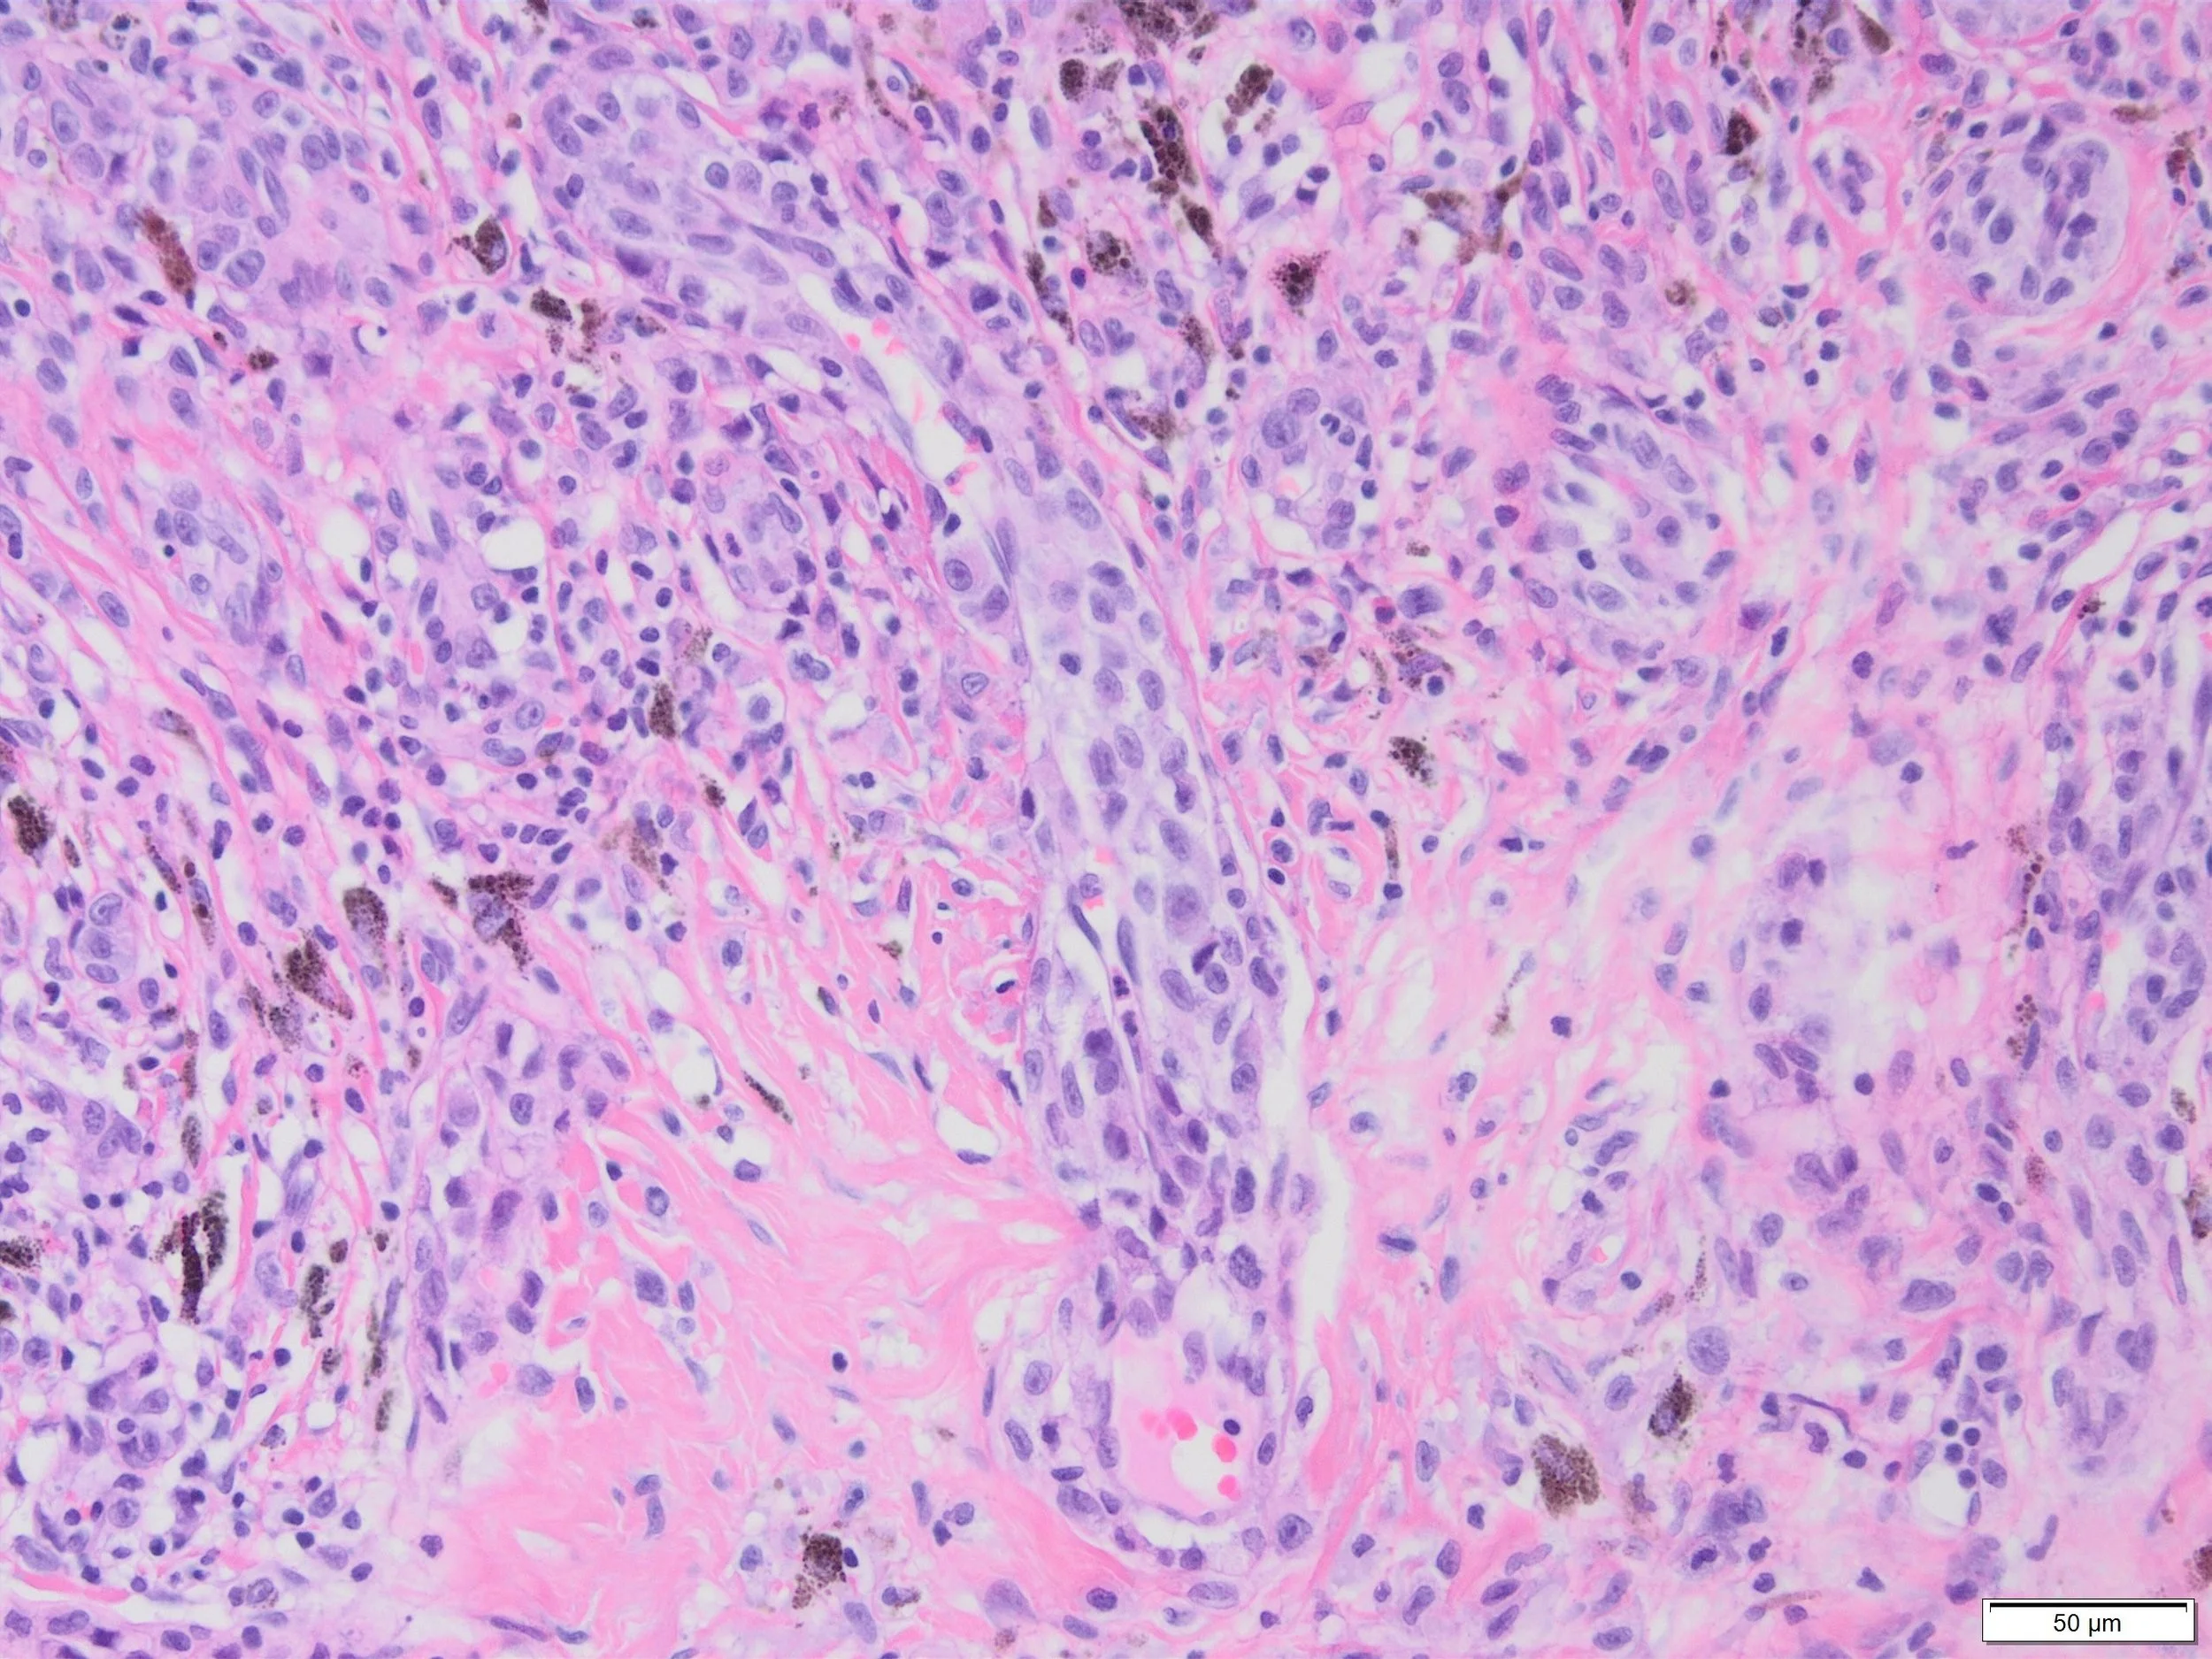

Clinical: Male 83, melanoma anterior shoulder.
Dr Alexander Nirenberg
MICROSCOPY:
The lesion is an invasive melanoma in sun-damaged skin, Breslow thickness 1.4mm, dermal mitotic rate 6/sq. mm.
What is the phenomenon demonstrated in the images from the melanoma?
View the case images below. Once viewed you can click here to download discussion
If you would like to submit a case for consideration, please contact the ADS Education Officer, Dr Ben Tallon via the secretariat at ads@arinex.com.au